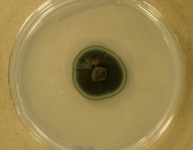

<< back to search
IMAGES:





Search Details
add to cart
| UAMH Number: | 3535 |
|---|---|
| Species Name: | Acidomyces acidophilus |
| Type: | |
| Synonyms: | Scytalidium acidophilum |
| Taxonomy: | FUNGI Ascomycota, Dothideomycetes, Capnodiales, Teratosphaeriaceae |
| Strain History: | K.C. Iverson -> Cooke, F. (U of A, ex Iverson CDA, Ottawa) -> UAMH |
| Substrate: | acid uranium mine drainage water | Location: | CANADA (GEO: 58.337,-112.385) |
| Isolator: | K.C. Iverson |
| Isolation Date: | 1972 |
| Date Received: | 1972-10-11 |
| Characters: | LOW PH opt. pH 1 - // MESOPHILIC grows better at 25-30C than at 22C or 35C - // SYSTEMATICS/ TAXONOMY description - Sigler L, Carmichael JW, Canad J Microbiol 20:267-268, 1973 (Click for publications citing UAMH 3535) |
| Compounds: | ACIDOPHILIC XYLANASE Al Balaa et al, Biosci Biotechnol Biochem 70:269-272, 2006 // SINGLE-CELL PROTEIN FROM WHEY & PULPMILL WASTE SULPHITE LIQUOR UNDER ACIDIC CONDITIONS Miller & al, International Biodeterioration 20:27-31, 1984 |
| Cross Reference: | ATCC 26774 // CBS 272.74 // CCFC005140 // DAOM 192478 // IMI 183521 |
| Collections: | Living Strains; Dried Herbarium Material |
| Pathogenic Potential: | Human: no | Animal: no | Plant: no |
| Biosafety Risk Group: | RG1 (check the PHAC ePATHogen Risk Group Database for updates) |
| Regulatory Requirements: | No restrictions for Canadian requesters. International requesters must provide all legally required importation documentation prior to shipment. Plant pathogenicity status may be verified by using the USDA Agricultural Research Service (ARS) Fungal Database |
| MycoBank ID: | 511856 |
| Sequences: | >UAMH03535_UAMH_ITS CATTACCGAGTGAGGGCTCCGGCCCGACCTCCGACCCCACACCTTCCAACCCCCTCGTACCTGGGGGGTGACCCGGCCGCGCGCCGGGGCCCCCACGGGACCTCTCCAACCCTGTCTTATCGAGCGTCTGAGCGTAAAAGCGAAATCAAACAAAACTTTCAACAACGGATCTCTTGGTTCTGGCATCGATGAAGAACGCAGCGAAATGCGATAAGTAATGTGAATTGCAGAATTCAGTGAATCATCGAATCTTTGAACGCACATTGCGCCCCTTGGTATTCCGGGGGGCATGCCTGTTCGAGCGTCATTACACCACTCCAGCCCGGCTGGGTATTGGGCGCCGCGGCGATCGCCGCGCGCCTCAAACGCCGTCCGGCCCGGCCGTCCGTCCCCGAGCGTTGCGGTACTTTGTTCAGTCGCTCGGTGGGTATGGGCGGCGGCGCGCCGTAAAACCTCCTTTCAGGTTGACCTCGGATCAGGTAGGGATACCCGCTGAACTTAAGCATATCAATAAGCGGAGGAAAAGAAACCAACAGGGATTGCCCTAGTAACGGCGAGTGAAGCGGCAACAGCTCAAATTTGAAATCTGGCGCAAGCCCGAGTTGTAATTTGTAGAGGATGCTTCAGGGCAGCGGCCGTTCTAAGTCTTTTGGAACAAGGCGTCACAGA |
IMAGES: